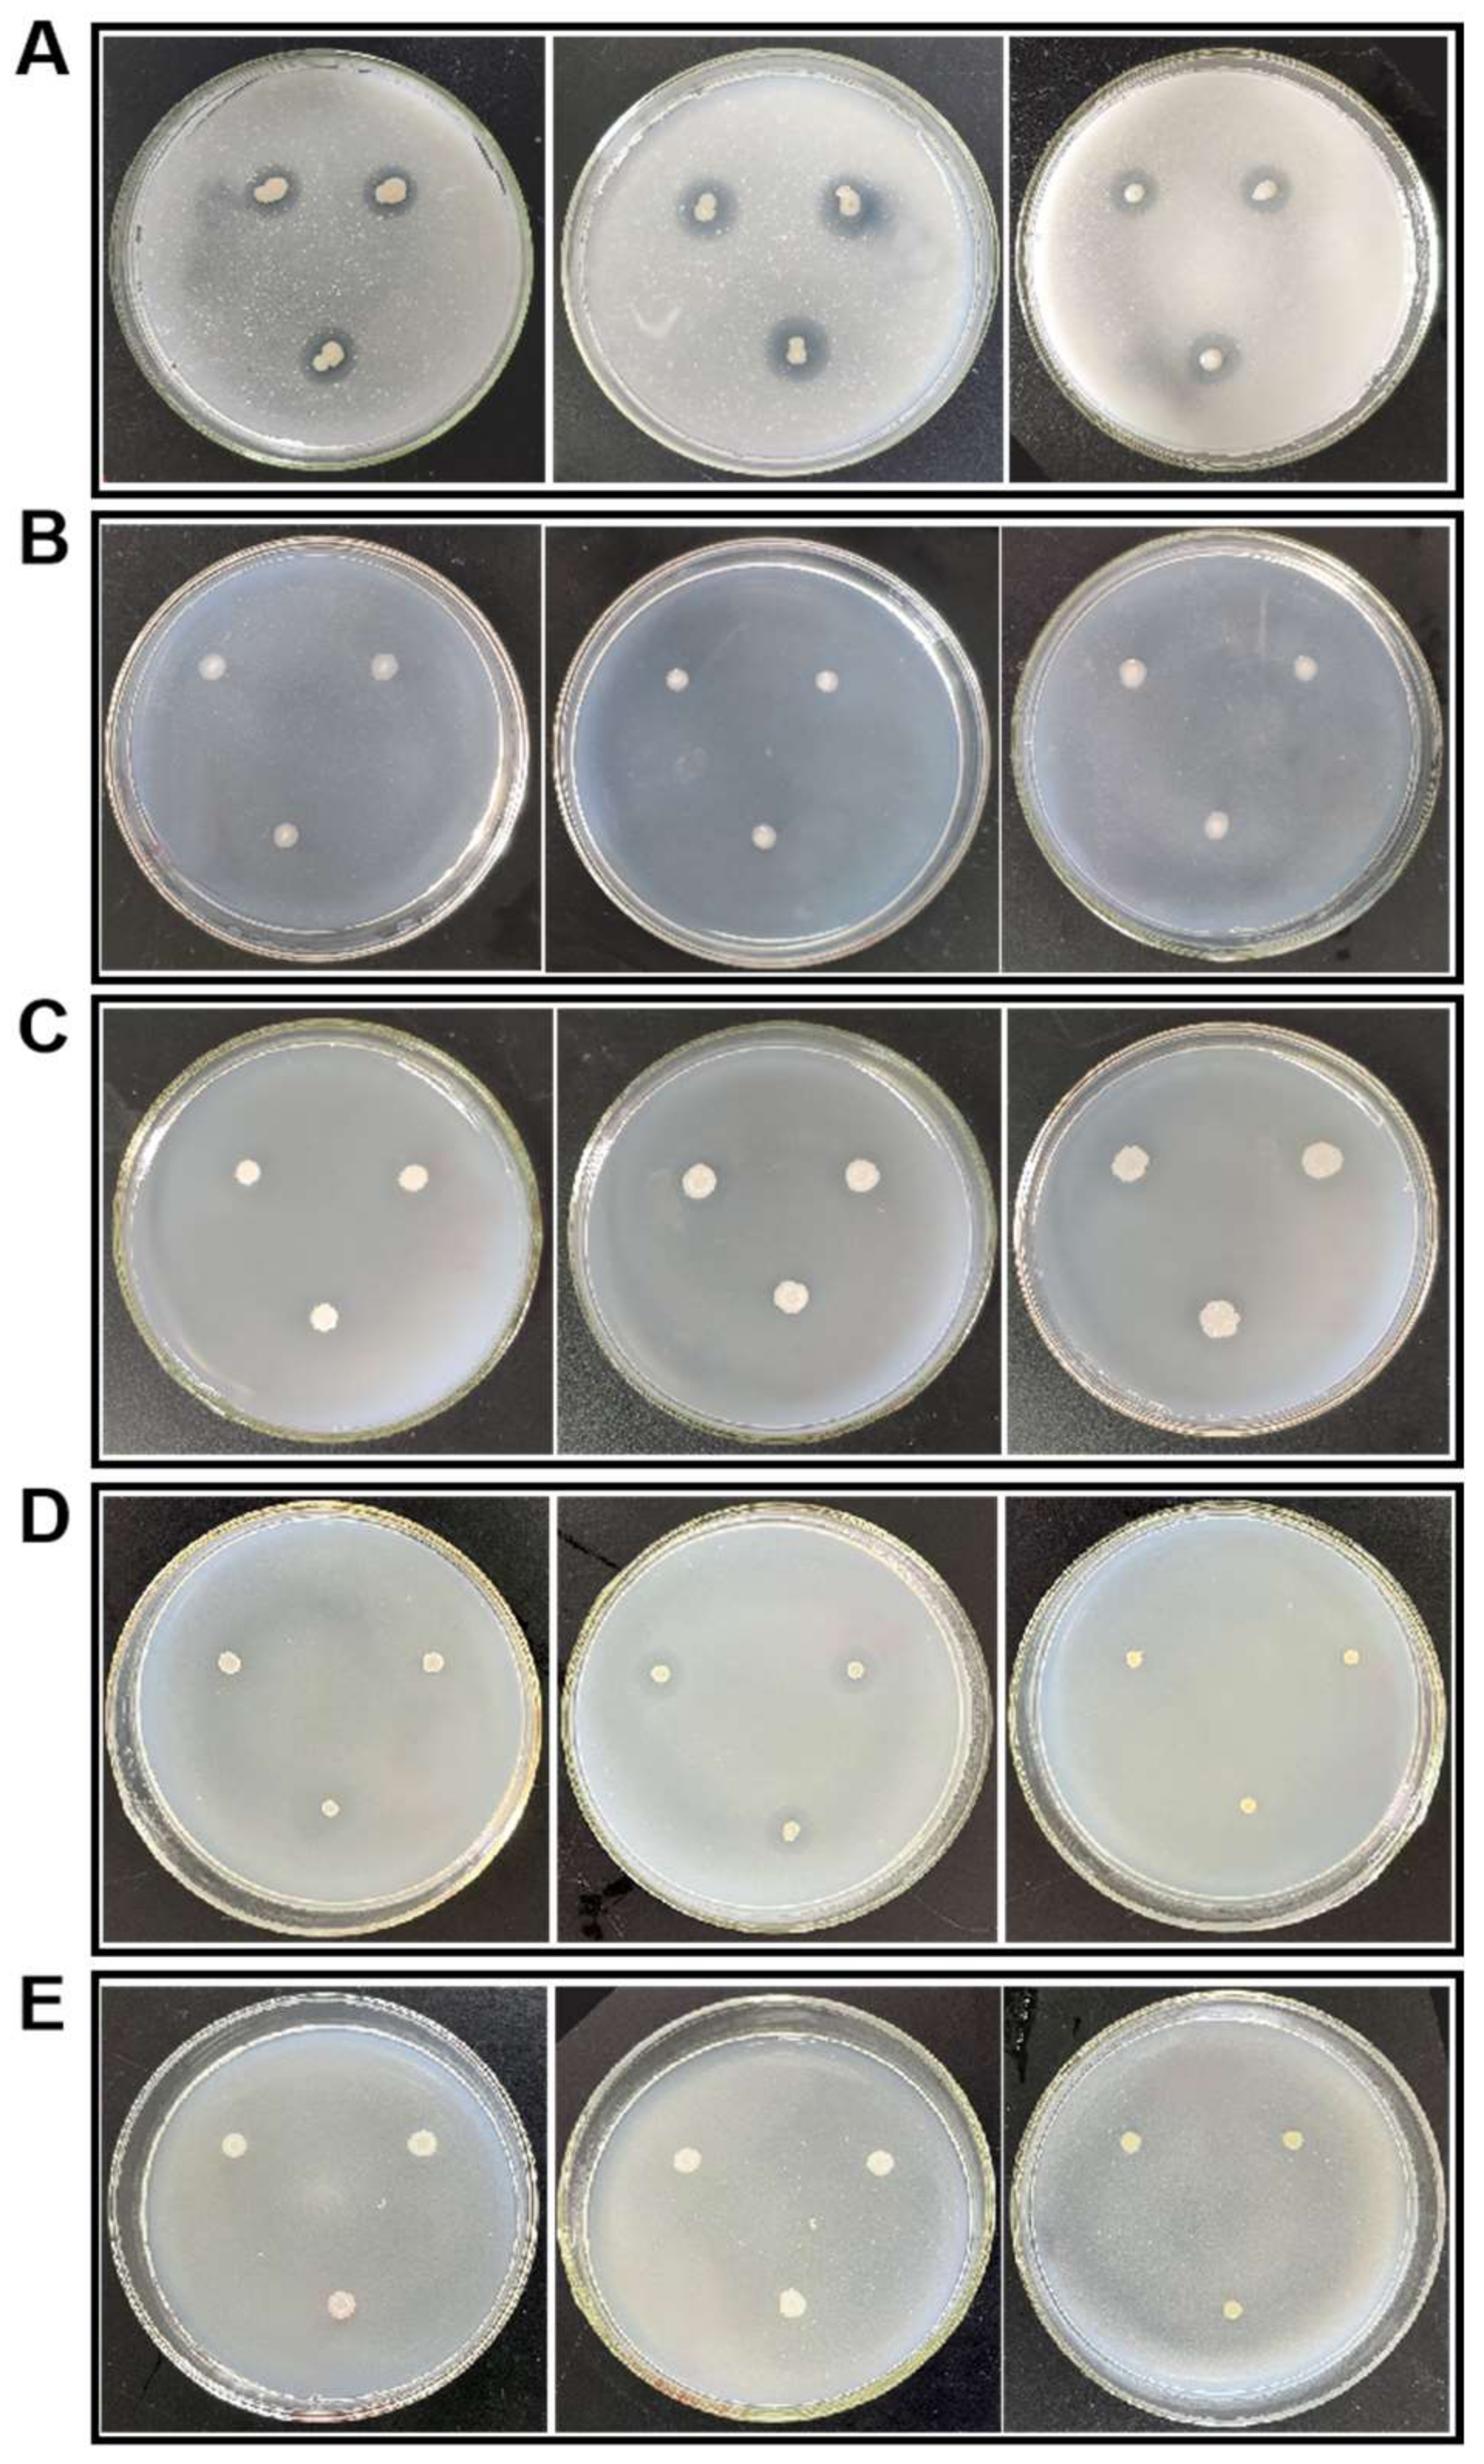
Plants 13 00329 g008

Characterization of Rhizosphere Microbial Diversity and Selection of Plant-Growth-Promoting Bacteria at the Flowering and Fruiting Stages of Rapeseed
Abstract
1. Introduction
2. Results
2.1. Microbial Communities in Rapeseed Rhizosphere Soil
2.2. Comparison of Microbial Community Diversity in Rapeseed Rhizosphere Soil
2.3. Screening the PGPR Strains in the Rhizosphere Soil of Flowering and Fruiting Rapeseed
3. Discussion
3.1. Microbial Communities in Rapeseed Rhizosphere Soil
3.2. Screening the PGPR Strains in the Rhizosphere Soil of Flowering and Fruiting Rapeseed
4. Materials and Methods
4.1. Collection of Soil Samples
4.2. Analysis of DNA Sequences of Microbes in Soil Sample
4.3. Screening and Isolation of PGPR Strains in Different Stages of Rapeseed Growth
4.4. Data Analysis
5. Conclusions
Supplementary Materials
Author Contributions
Funding
Data Availability Statement
Conflicts of Interest
References
- Mason, A.S.; Snowdon, R.J. Oilseed rape: Learning about ancient and recent polyploid evolution from a recent crop species. Plant Biol. 2016, 18, 883–892. [Google Scholar] [CrossRef] [PubMed]
- Liu, Y.; Gao, J.; Bai, Z.; Wu, S.; Li, X.; Wang, N.; Du, X.; Fan, H.; Zhuang, G.; Zhuang, X. Unraveling mechanisms and impact of microbial recruitment on rapeseed (Brassica napus L.) and the rhizosphere mediated by plant growth-promoting rhizobacteria. Microorganisms 2021, 9, 161. [Google Scholar] [CrossRef] [PubMed]
- Fang, X.; Wang, H.; Zhao, L.; Wang, M.; Sun, M. Diversity and structure of the rhizosphere microbial communities of wild and cultivated ginseng. BMC Microbiol. 2022, 22, 2. [Google Scholar] [CrossRef] [PubMed]
- Jacoby, R.; Peukert, M.; Succurro, A.; Koprivova, A.; Kopriva, S. The role of soil microorganisms in plant mineral nutrition—Current knowledge and future directions. Front. Plant Sci. 2017, 8, 1617. [Google Scholar] [CrossRef] [PubMed]
- Santoyo, G.; Urtis-Flores, C.A.; Loeza-Lara, P.D.; Orozco-Mosqueda, M.D.C.; Glick, B.R. Rhizosphere colonization determinants by plant growth-promoting rhizobacteria (PGPR). Biology 2021, 10, 475. [Google Scholar] [CrossRef] [PubMed]
- Olanrewaju, O.S.; Ayangbenro, A.S.; Glick, B.R.; Babalola, O.O. Plant health: Feedback effect of root exudates-rhizobiome interactions. Appl. Microbiol. Biotechnol. 2019, 103, 1155–1166. [Google Scholar] [CrossRef] [PubMed]
- Martinoia, E.; Northen, T. Feed your friends: Do plant exudates shape the root microbiome? Trends Plant Sci. 2018, 23, 25–41. [Google Scholar]
- Wang, M.; Deng, B.; Fu, X.; Sun, H.; Xu, Z. Characterizations of microbial diversity and machine oil degrading microbes in machine oil contaminated soil. Environ. Pollut. 2019, 255, 113190. [Google Scholar] [CrossRef]
- Trivedi, P.; Leach, J.E.; Tringe, S.G.; Sa, T.; Singh, B.K. Plant-microbiome interactions: From community assembly to plant health. Nat. Rev. Microbiol. 2020, 18, 607–621. [Google Scholar] [CrossRef]
- Wang, M.; Sun, H.; Xu, Z. Analysis of blueberry plant rhizosphere bacterial diversity and selection of plant growth promoting rhizobacteria. Curr. Microbiol. 2022, 79, 331. [Google Scholar] [CrossRef]
- Meena, M.; Swapnil, P.; Divyanshu, K.; Kumar, S.; Harish; Tripathi, Y.N.; Zehra, A.; Marwal, A.; Upadhyay, R.S. PGPR-mediated induction of systemic resistance and physiochemical alterations in plants against the pathogens: Current perspectives. J. Basic Microbiol. 2020, 60, 828–861. [Google Scholar] [CrossRef] [PubMed]
- Vejan, P.; Abdullah, R.; Khadiran, T.; Ismail, S.; Nasrulhaq, B.A. Role of plant growth promoting rhizobacteria in agricultural sustainability—A Review. Molecules 2016, 21, 573. [Google Scholar] [CrossRef] [PubMed]
- Bhattacharyya, P.N.; Jha, D.K. Plant growth-promoting rhizobacteria (PGPR): Emergence in agriculture. World J. Microbiol. Biotechnol. 2012, 28, 1327–1350. [Google Scholar] [CrossRef] [PubMed]
- Martinez-Viveros, O.; Jorquera, M.A.; Crowley, D.E.; Gajardo, G.; Mora, M.L. Mechanisms and practical considerations involved in plant growth promotion by rhizobacteria. J. Soil Sci. Plant Nutr. 2010, 10, 293–319. [Google Scholar] [CrossRef]
- Giannelli, G.; Potestio, S.; Visioli, G. The contribution of PGPR in salt stress tolerance in crops: Unravelling the molecular mechanisms of cross-talk between plant and bacteria. Plants 2023, 12, 2197. [Google Scholar] [CrossRef] [PubMed]
- Kumar, A.; Dubey, A. Rhizosphere microbiome: Engineering bacterial competitiveness for enhancing crop production. J. Adv. Res. 2020, 24, 337–352. [Google Scholar] [CrossRef] [PubMed]
- Vyas, P.; Kumar, A.; Kumar, D.; Dubey, A. Screening and characterization of achromobacter xylosoxidans isolated from rhizosphere of Jatropha curcas L. (energy crop) for plant-growth-promoting traits. J. Adv. Res. Biotechnol. 2018, 3, 1–8. [Google Scholar]
- Bulgarelli, D.; Schlaeppi, K.; Spaepen, S.; van Themaat, E.V.L.; Schulze-Lefert, P. Structure and functions of the bacterial microbiota of plants. Annu. Rev. Plant Biol. 2013, 64, 807–838. [Google Scholar] [CrossRef]
- Tariq, M.; Noman, M.; Ahmed, T.; Manzoor, N.; Zafar, M. Antagonistic features displayed by plant growth promoting rhizobacteria (PGPR): A review. J. Plant Sci. Phytopathol. 2017, 1, 38–43. [Google Scholar]
- Galindo-Castañeda, T.; Hartmann, M.; Lynch, J.P. Location: Root architecture structures rhizosphere microbial associations. J. Exp. Bot. 2023, 75, 594–604. [Google Scholar] [CrossRef]
- Jenkins, S.N.; Waite, I.S.; Blackburn, A.; Husband, R.; Rushton, S.P.; Manning, D.C.; O’Donnell, A.G. Actinobacterial community dynamics in long term managed grasslands. Antonie Leeuwenhoek 2009, 95, 319–334. [Google Scholar] [CrossRef] [PubMed]
- Gupta, R.; Anand, G.; Gaur, R.; Yadav, D. Plant–microbiome interactions for sustainable agriculture: A review. Physiol. Mol. Biol. Plants 2021, 27, 165–179. [Google Scholar] [CrossRef] [PubMed]
- Andrew, T.; Giguere Stephanie, A.; Eichorst Dagmar, W. Acidobacteria are active and abundant members of diverse atmospheric H2-oxidizing communities detected in temperate soils. ISME J. 2021, 15, 363–376. [Google Scholar]
- Oshiki, M.; Toyama, Y.; Suenaga, T.; Terada, A.; Kasahara, Y.; Yamaguchi, T.; Araki, N. N2O Reduction by gemmatimonas aurantiaca and potential involvement of gemmatimonadetes bacteria in N2O reduction in agricultural soils. Microbes Environ. 2022, 37, ME21090. [Google Scholar] [CrossRef] [PubMed]
- Galperin, M.Y.; Kristensen, D.M.; Makarova, K.S.; Wolf, Y.; Koonin, E.V. Microbial genome analysis: The COG approach. Brief. Bioinform. 2019, 20, 1063–1070. [Google Scholar] [CrossRef] [PubMed]
- Gao, M.; Zhang, Z. Effects of dinbutyl phthalate on rhizosphere and non-rhizosphere soil microbial communities at different growing stages of wheat. Ecotoxicol. Environ. Saf. 2019, 174, 658–666. [Google Scholar] [CrossRef] [PubMed]
- Ivanova, A.A.; Oshkin, I.Y.; Danilova, O.V.; Philippov, D.A.; Ravin, N.V.; Dedysh, S.N. Rokubacteria in Northern Peatlands: Habitat Preferences and Diversity Patterns. Microorganisms 2021, 10, 11. [Google Scholar] [CrossRef] [PubMed]
- Zhao, C.; Yin, X.; Chen, J.; Cao, F.; Abou-Elwafa, S.; Huang, M. Effect of rapeseed straw-derived biochar on soil bacterial community structure at tillering stage of Oryza Sativa. Can. J. Microbiol. 2022, 68, 483–492. [Google Scholar] [CrossRef]
- Taylor, T.N.; Krings, M.; Taylor, E.L. 7—Glomeromycota. In Fossil Fungi; Academic Press: Cambridge, MA, USA, 2015; pp. 103–128. [Google Scholar]
- Yadav, A.; Batra, D.; Kaushik, P.K.; Mohanta, T.K. Abundance and distribution of arbuscular mycorrhizal fungi associated with oil-yielding plants. J. Basic Microbiol. 2023, 63, 814–827. [Google Scholar] [CrossRef]
- Cline, L.C.; ZaK, D.R. Soil microbial communities are shaped by plant-driven changes in resource availability during secondary succession. Ecology 2015, 96, 3374–3385. [Google Scholar] [CrossRef]
- Ma, Z.; Zhao, W.; Zhao, C.; Wang, D.; Liu, M.; Li, D.; Liu, Q. Plants regulate the efects of experimental warming on the soil microbial community in an alpine scrub ecosystem. PLoS ONE 2018, 13, e0195079. [Google Scholar]
- Liang, Q.; Long, R.; Li, S.; Jiang, C. Bacterial diversity of middle ear cholesteatoma by 16S rRNA gene sequencing in China. Funct. Integr. Genom. 2023, 23, 138. [Google Scholar] [CrossRef] [PubMed]
- Liu, S.; Sun, Y.; Shi, F.; Liu, Y.; Wang, F.; Dong, S.; Li, M. Composition and diversity of soil microbial community associated with land use types in the agro-pastoral area in the upper yellow river basin. Front. Plant Sci. 2022, 13, 819661. [Google Scholar] [CrossRef] [PubMed]
- Gao, L.; Lu, Z.; Ding, L.; Guo, J.; Wang, M.; Ling, N.; Guo, S.; Shen, Q. Role of aquaporins in determining carbon and nitrogen status in higher plants. Int. J. Mol. Sci. 2018, 19, 35. [Google Scholar] [CrossRef]
- Wang, M.; Shen, Q.; Xu, G.; Guo, S. New insight into the strategy for nitrogen metabolism in plant cells. Int. Rev. Cell Mol. Biol. 2014, 310, 1–37. [Google Scholar] [PubMed]
- Elser, J.J.; Fagan, W.F.; Kerkhoff, A.J.; Swenson, N.G.; Enquist, B.J. Biological stoichiometry of plant production: Metabolism, scaling and ecological response to global change. New Phytol. 2010, 186, 593–608. [Google Scholar] [CrossRef] [PubMed]
- Sonali Grewal, S.K.; Gill, R.K. Insights into carbon and nitrogen metabolism and antioxidant potential during vegetative phase in quinoa (Chenopodium quinoa Willd.). Protoplasma 2022, 259, 1301–1319. [Google Scholar] [CrossRef]
- Yue, H.; Yue, W.; Jiao, S.; Kim, H.; Lee, Y.H.; Wei, G.; Song, W.; Shu, D. Plant domestication shapes rhizosphere microbiome assembly and metabolic functions. Microbiome 2023, 11, 70. [Google Scholar] [CrossRef]
- Tripathi, R.; Tewari, R.; Singh, K.P.; Keswani, C.; Minkina, T.; Srivastava, A.K.; De Corato, U.; Sansinenea, E. Plant mineral nutrition and disease resistance: A significant linkage for sustainable crop protection. Front. Plant Sci. 2022, 13, 883970. [Google Scholar] [CrossRef]
- Nagrale, D.T.; Chaurasia, A.; Kumar, S.; Gawande, S.P.; Hiremani, N.S.; Shankar, R.; Gokte-Narkhedkar, N.; Renu Prasad, Y.G. PGPR: The treasure of multifarious beneficial microorganisms for nutrient mobilization, pest biocontrol and plant growth promotion in field crops. World J. Microbiol. Biotechnol. 2023, 39, 100. [Google Scholar] [CrossRef]
- Sapre, S.; Gontia-Mishra, I.; Tiwari, S. Klebsiella sp. confers enhanced tolerance to salinity and plant growth promotion in oat seedlings (Avena sativa). Microbiol. Res. 2017, 206, 25–32. [Google Scholar] [CrossRef]
- Ahmad, M.; Zahir, Z.A.; Nazli, F.; Akram, F.; Arshad, M.; Khalid, M. Effectiveness of halo-tolerant, auxin producing Pseudomonas and Rhizobium strains to improve osmotic stress tolerance in mung bean (Vigna radiata L.). Braz. J. Microbiol. 2014, 44, 1341–1348. [Google Scholar] [CrossRef] [PubMed]
- Alaylar, B.; Güllüce, M.; Karadayi, M.; Isaoglu, M. Rapid detection of phosphate-solubilizing bacteria from agricultural areas in Erzurum. Curr. Microbiol. 2019, 76, 804–809. [Google Scholar] [CrossRef] [PubMed]
- Li, Y.; You, X.; Tang, Z.; Zhu, T.; Liu, B.; Chen, M.; Xu, Y.; Liu, T. Isolation and identification of plant growth-promoting rhizobacteria from tall fescue rhizosphere and their functions under salt stress. Physiol. Plant 2022, 174, e13817. [Google Scholar] [CrossRef]
- Stephan, R.; van Trappen, S.; Cleenwerck, I.; Iversen, C.; Joosten, H.; De-Vos, P.; Leher, A. Enterobacter pulveris sp. nov., isolated from fruit powder, infant formula and an infant formula production environment. Int. J. Syst. Evol. Microbiol. 2008, 58, 237–241. [Google Scholar] [CrossRef] [PubMed]
- Kämpfer, P.; Ruppel, S.; Remus, R. Enterobacter radicincitans sp. nov., a plant growth promoting species of the family Enterobacteriaceae. Syst. Appl. Microbiol. 2005, 28, 213–221. [Google Scholar] [CrossRef] [PubMed]
- Gupta, R.; Khan, F.; Alqahtani, F.M.; Hashem, M.; Ahmad, F. Plant growth-promoting rhizobacteria (PGPR) assisted bioremediation of heavy metal toxicity. Appl. Biochem. Biotechnol. 2023. [Google Scholar] [CrossRef] [PubMed]
- Raspanti, E.; Cacciola, S.O.; Gotor, C.; Romero, L.C.; García, I. Implications of cysteine metabolism in the heavy metal response in Trichoderma harzianum and in three Fusarium species. Chemosphere 2009, 76, 48–54. [Google Scholar] [CrossRef]
- Muratova, A.; Golubev, S.; Romanova, V.; Sungurtseva, I.; Nurzhanova, A. Effect of heavy-metal-resistant PGPR inoculants on growth, rhizosphere microbiome and remediation potential of miscanthus × giganteus in Zinc-contaminated Soil. Microorganisms 2023, 11, 1516. [Google Scholar] [CrossRef]
- Shahid, M.; Zeyad, M.T.; Syed, A.; Singh, U.B.; Mohamed, A.; Bahkali, A.H.; Elgorban, A.M.; Pichtel, J. Stress-tolerant endophytic isolate Priestia aryabhattai BPR-9 modulates physio-biochemical mechanisms in wheat (Triticum aestivum L.) for enhanced salt tolerance. Int. J. Environ. Res. Public Health 2022, 19, 10883. [Google Scholar] [CrossRef]
- Zelaya-Molina, L.X.; Guerra-Camacho, J.E.; Ortiz-Alvarez, J.M.; Vigueras-Cortés, J.M.; Villa-Tanaca, L.; Hernández-Rodríguez, C. Plant growth-promoting and heavy metal-resistant Priestia and Bacillus strains associated with pioneer plants from mine tailings. Arch. Microbiol. 2023, 205, 318. [Google Scholar] [CrossRef] [PubMed]
- Kelany, M.S.; El-Sawy, M.A.; El-Gendy, A.R.; Beltagy, E.A. Bioremediation of industrial wastewater heavy metals using solo and consortium Enterobacter spp. Environ. Monit. Assess. 2023, 195, 1357. [Google Scholar] [CrossRef] [PubMed]
- Ning, X.; Wang, S.; Long, S.; Li, L.; Dong, S.; Nan, Z. The role of Fe-oxidizing bacteria (FeOB) and organic matters in As removal in the heavy-polluted arid soil. Ecotoxicol. Environ. Saf. 2022, 245, 114126. [Google Scholar] [CrossRef] [PubMed]
- Wang, M.; Sun, H.; Xu, L.; Xu, Z. Bacterial diversity in tea plant (Camellia sinensis) rhizosphere soil from Qinling Mountains and its relationship with environmental elements. Plant Soil 2021, 460, 403–415. [Google Scholar] [CrossRef]
- Cox, J.A. Electrochemical Method for the Determination of Phosphate in Natural Water; Water Research Center Research Report; University of Illinois at Urbana-Champaign, Water Resources Center: Champaign, IL, USA, 1972. [Google Scholar]
- Da Silva, J.F.; da Silva, T.R.; Escobar, I.E.C.; Fraiz, A.C.R.; Dos Santos, J.W.M.; do Nascimento, T.R.; Dos Santos, J.M.R.; Peters, S.J.; de Melo, R.F.; Signor, D. Screening of plant growth promotion ability among bacteria isolated from feld-grown sorghum under diferent managements in Brazilian drylands. World J. Microbiol. Biotechnol. 2018, 34, 186–193. [Google Scholar] [CrossRef] [PubMed]
- Jiang, C.; Sheng, X.; Qian, M.; Wang, Q. Isolation and characterization of a heavy metal-resistant Burkholderia sp. from heavy metal-contaminated paddy field soil and its potential in promoting plant growth and heavy metal accumulation in metal-polluted soil. Chemosphere 2008, 72, 157–164. [Google Scholar] [CrossRef]

| Sample | Bacteria | ||
|---|---|---|---|
| Chao1 | Shannon | Simpson | |
| YCK | 708.000 ± 10.186 a | 0.991 ± 0.003 a | 7.995 ± 0.200 a |
| YF | 821.376 ± 54.649 b | 0.989 ± 0.001 a | 7.946 ± 0.194 a |
| YS | 1036.071 ± 31.969 c | 0.995 ± 0.000 a | 8.637 ± 0.053 b |
| Fungus | |||
| Chao1 | Shannon | Simpson | |
| YCK | 127.259 ± 13.351 a | 0.875 ± 0.077 b | 4.323 ± 0.641 a |
| YF | 144.446 ± 11.752 a | 0.510 ± 0.087 c | 2.711 ± 0.223 b |
| YS | 178.531 ± 8.342 ab | 0.899 ± 0.086 a | 2.387 ± 0.111 b |
| Scheme | Accession Number | Sequence Length (bp) | Related Type Strain | Type Strain Name | NCBI Taxonomy ID | Similarity to Type Strain (%) |
|---|---|---|---|---|---|---|
| YS22 | OR234767 | 1112 | Acinetobacter sp. | - | - | - |
| YS36 | OR234768 | 1127 | Enterobacter sp. | - | - | - |
| YS31 | OR234769 | 949 | Klebsiella sp. | - | - | - |
| YS23 | OR234770 | 1163 | Lelliottia amnigena | DSM 4486T | 61,646 | 99% |
| YF28 | OR234771 | 845 | Pseudomonas azotoformans | DSM 18862 | 47,878 | 99% |
| YS12 | OR234772 | 1207 | Pseudomonas flavescens | DSM 12071 | 29,435 | 99% |
| YF13 | OR234773 | 1185 | Pseudomonas frederiksbergensis | DSM 13022 | 104,087 | 99% |
| YS66 | OR234774 | 1042 | Pseudomonas jessenii | DSM 17150 | 77,298 | 99% |
| YF66 | OR234775 | 1118 | Pseudomonas reinekei | DSM 18361 | 395,598 | 99% |
| YS24 | OR234776 | 1150 | Pseudomonas umsongensis | DSM 16611 | 198,618 | 99% |
| YF15 | OR234777 | 1086 | Pseudomonas sp. | - | - | - |
| YS20 | OR234778 | 1196 | Stenotrophomonas maltophilia | DSM 50170 | 40,324 | 99% |
| YS67 | OR234779 | 1191 | Stenotrophomonas sp. | - | - | - |
| YS13 | OR234782 | 1020 | Bacillus subtilis | ATCC 6051 | 1423 | 99% |
| YS44 | OR234783 | 1149 | Bacillus sp. | - | - | - |
| YF3 | OR234784 | 1040 | Fictibacillus sp. | - | - | - |
| YS65 | OR234785 | 1056 | Priestia aryabhattai | DSM 21047 | 99% | |
| YF30 | OR234780 | 1200 | Priestia huizhouensis | KCTC 33172 | 1,501,239 | 99% |
| YF57 | OR234781 | 1142 | Priestia megaterium | ATCC 14581 | 1404 | 99% |
| Sample | Longitude | Latitude | Altitude (m) | pH |
|---|---|---|---|---|
| YCK | 106°39′58″ E–106°39′40″ E | 32°57′29″ N–32°57′43″ N | 618.5 m–619.2 m | 6.56 ± 0.087 |
| YF/YS | 106°39′7″ E–106°39′21″ E | 32°57′56″ N–32°56′41″ N | 619.5 m–620.5 m | 6.50 ± 0.012 |
Disclaimer/Publisher’s Note: The statements, opinions and data contained in all publications are solely those of the individual author(s) and contributor(s) and not of MDPI and/or the editor(s). MDPI and/or the editor(s) disclaim responsibility for any injury to people or property resulting from any ideas, methods, instructions or products referred to in the content. |
© 2024 by the authors. Licensee MDPI, Basel, Switzerland. This article is an open access article distributed under the terms and conditions of the Creative Commons Attribution (CC BY) license (https://creativecommons.org/licenses/by/4.0/).
Share and Cite
Wang, M.; Sun, H.; Xu, Z. Characterization of Rhizosphere Microbial Diversity and Selection of Plant-Growth-Promoting Bacteria at the Flowering and Fruiting Stages of Rapeseed. Plants 2024, 13, 329. https://doi.org/10.3390/plants13020329
Wang M, Sun H, Xu Z. Characterization of Rhizosphere Microbial Diversity and Selection of Plant-Growth-Promoting Bacteria at the Flowering and Fruiting Stages of Rapeseed. Plants. 2024; 13(2):329. https://doi.org/10.3390/plants13020329
Chicago/Turabian StyleWang, Mengjiao, Haiyan Sun, and Zhimin Xu. 2024. "Characterization of Rhizosphere Microbial Diversity and Selection of Plant-Growth-Promoting Bacteria at the Flowering and Fruiting Stages of Rapeseed" Plants 13, no. 2: 329. https://doi.org/10.3390/plants13020329
APA StyleWang, M., Sun, H., & Xu, Z. (2024). Characterization of Rhizosphere Microbial Diversity and Selection of Plant-Growth-Promoting Bacteria at the Flowering and Fruiting Stages of Rapeseed. Plants, 13(2), 329. https://doi.org/10.3390/plants13020329

